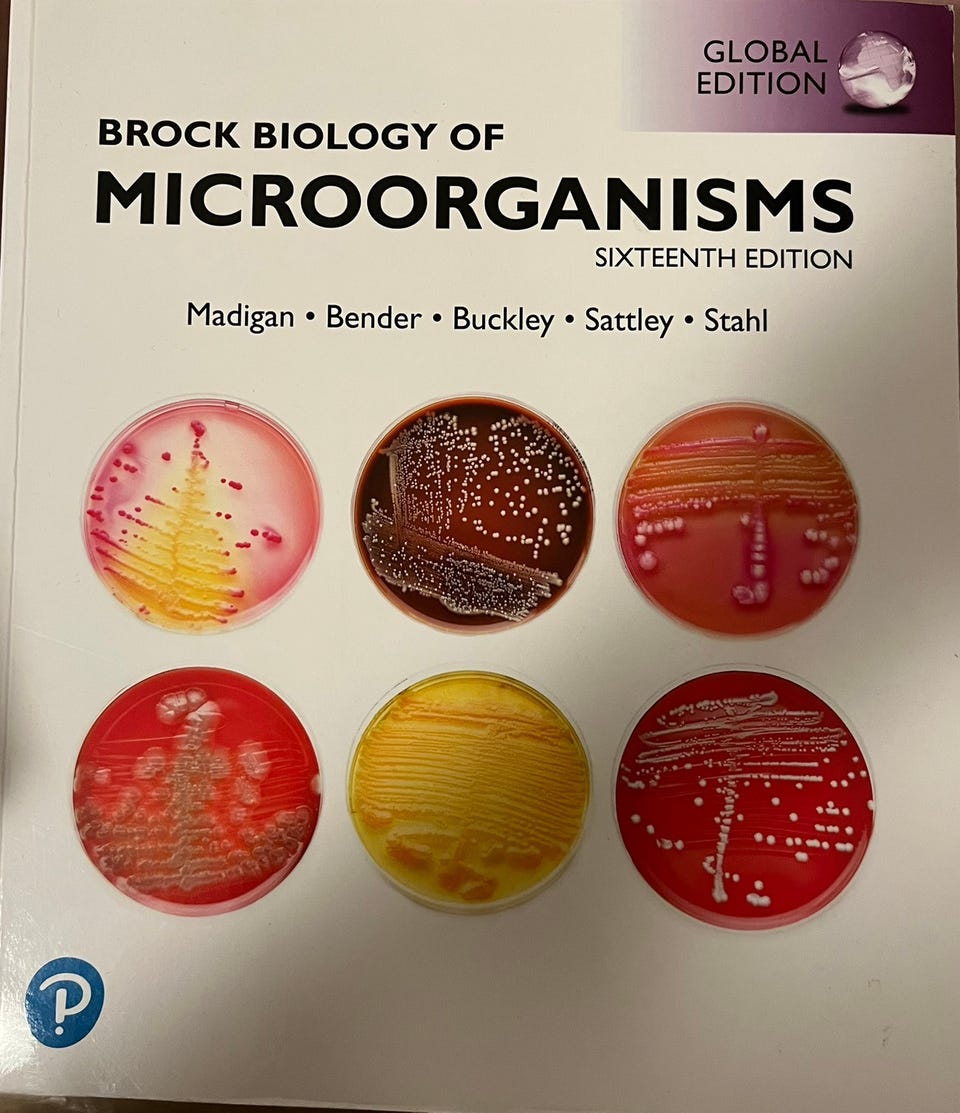
Galleribilde

Bildegalleri
(1/10)
Farmasibøker: kjemi, biologi, etikk
Inaktiv
Til salgs
200 kr
Beskrivelse av varen
Tilstand: Pent brukt - I god stand
Emne: Helse og medisin
Selger pensumbøker til farmasi. Noen inneholder merker. Si ifra hvis du vil jeg skal fjerne klistrelapper.
Klein’s chemistry Global edition- 400kr
Chemistry: The molecular nature of matter and change 9e - 500kr
Almen Farmaci 4.utgave - 150kr SOLGT
an introduction to medicinal chemistry 6th edition - 250kr
Brock biology of microorganisms 16th edition - 600kr SOLGT
Essential cell biology 5th edition- 500kr
Aulton’s pharmaceutics 5th edition - 300kr
Introduction to pharmaceutical analytical chemistry 2nd edition - 300kr SOLGT
Etikk i sykepleien 5.utgave - 200kr
NB: Knappen for å vise hele beskrivelsen har kun en visuell effekt.
Brukerprofil

Du må være logget inn for å se brukerprofiler og sende meldinger.
Logg innAnnonsens metadata
Sist endret: 4.4.2025 kl. 16:55 ・ FINN-kode: 388681639